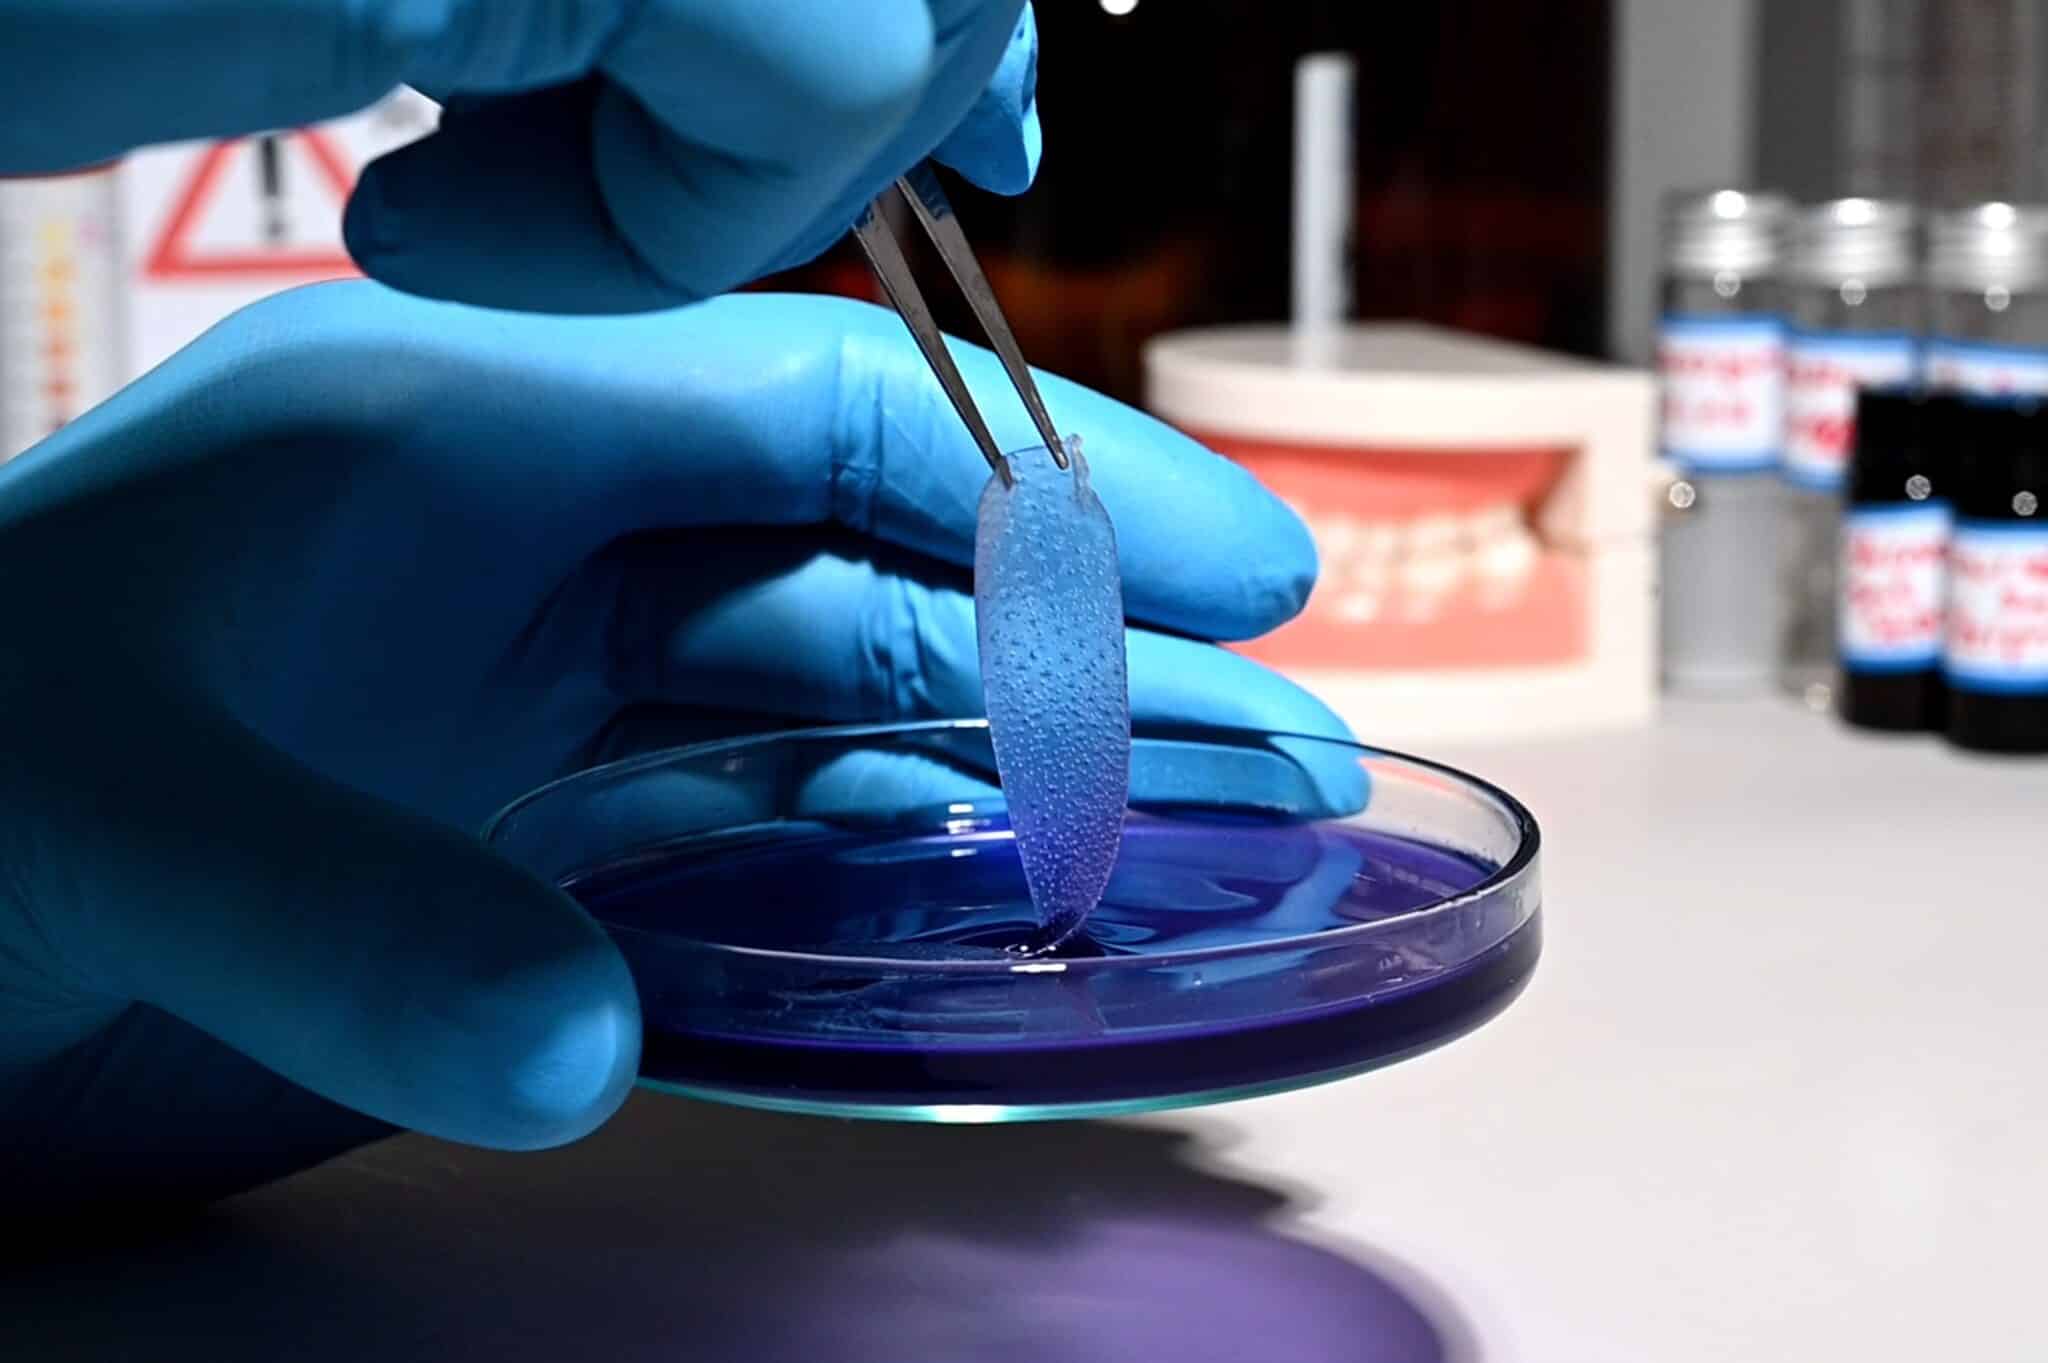
Vorsicht vor riskanten Trendprodukten

10 Products Rated “Poor”: The 5 Best and Safest Teeth-Whitening Products for 2026
36
Zahnaufheller
200
Tage getestet
10
Durchgefallen

Teeth Whitening: Not Every “Hollywood Smile” Is Healthy
Brilliant white teeth are widely associated with attractiveness and good health1. Unsurprisingly, the teeth whitening market is booming.
Wherever you look – whether it’s influencer ads across social media, drugstore shelves, or online retailers – the promise of an instant Hollywood smile seems just a click away.
But do these teeth whitening products really deliver on the glossy promises in their marketing?
Teeth Whitening Under Scrutiny: Winners, Flops, and Risks
In partnership with dental experts, we subjected over 30 popular at-home whitening products to rigorous evaluation — including high-tech LED kits, strips, and trending products like violet “colour corrector gels”.
The bottom line: Only a handful of products impressed us. Many were flat-out ineffective, and some even carried risks for enamel and gums.
In short, if you choose the wrong product, you may be putting your oral health at risk.
Be Wary of Risky Whitening Trends
Stubborn stains rarely budge with regular brushing. If you’re looking for a quick fix, it’s easy to fall for questionable offers.
“Cheaply made tooth whiteners from dubious brands or so-called miracle gels hyped on TikTok and Instagram expose consumers to unnecessary risks”, warns Dr. Rosmy Barrios.
“At best, many of these trending products do nothing; at worst, they can actively damage enamel and gums.”
International dental experts echo this assessment: Many over-the-counter whiteners exceed legal peroxide limits and can cause lasting harm2.
Trust Only the Judgement of Dental Experts
Here’s the good news: It is indeed possible to brighten your teeth at home. But it’s only risk-free when you turn to tested, safe whitening kits.
Just because a product sparkles online or racks up Instagram likes, doesn’t mean it’s actually safe.
This test report will show you how to spot a trustworthy whitener – and avoid high-risk pitfalls.
Whitening at Home: How to Find the Best Product

If you’re trying to get whiter teeth at home, you’re faced with an overwhelming array of options:
Between whitening strips, gels, miracle toothpastes, and modern LED kits, these differences that start with the whitening method itself.
Here’s what you’ll find in the following sections:
- Which methods yield the fastest visible results
- What to look for in good ingredients, and immediate warning signs
- What results you can realistically expect
- How to spot the right product using a simple criteria checklist
This way, choosing a whitener becomes a safe, informed decision — not a gamble.
Editor’s note: Want to skip ahead to the winners? Here’s the full ranking.
1 Which Teeth Whitening Methods Work Best?

For our review, we scrutinized 36 whitening products over 200 days of hands-on tests, ingredient analysis, and expert assessments.
Our goal: To help you pick the best whitening solution while avoiding unnecessary or risky mistakes.
Our tests included:
- LED whitening kits
- Whitening strips
- Whitening pens
- Whitening powders and toothpastes
- Purple colour corrector serums
During testing, huge differences emerged in terms of effectiveness, safety, and quality.
What performed best:
Less convincing:
Bottom line: For professional results and true safety, you need an LED kit with a proven whitening formula. In testing, strips, pastes, and powders fell far short of expectations and sometimes posed additional risks to dental health.
2 What Results Can You Reasonably Expect?
Our testing revealed a stark reality: Many OTC whitening products are ineffective, and only a select few can achieve dentist-level results.
Below, you’ll find what high quality, tested whitening products can actually accomplish.
Real-world examples from our tests:


Tested product: “Light & Bright” by Smilebite
Number of applications: Seven
Whitening: Five to six shades


Tested product: “Light & Bright” by Smilebite
Number of applications: Five
Whitening: Four to five shades


Tested product: Smilepro Teeth Whitening Kit
Number of applications: Eight
Whitening: Four to five shades


Tested product: “Light & Bright” by Smilebite
Number of applications: Ten
Whitening: Six to seven shades
As always, keep in mind: Both the speed and intensity of your results vary from person to person.




What you can realistically expect:
What you shouldn’t expect:
3 Which Ingredients Matter Most?

Your ingredient list determines a positive or negative outcome. When it comes to safety and efficacy in teeth whitening, the right ingredients make all the difference — they dictate the result, the tolerance, and protection for your teeth.
The Key Ingredients
What You Should Avoid
Warning: EU authorities have repeatedly pulled whitening products from the market due to excessive peroxide levels or undeclared ingredients34.
In our own test, we detected hidden peroxide and peroxide-like agents in a number of kits.
In short: For sustainably healthy, white teeth, your choice of safe, evidence-based ingredients makes all the difference.
One critical glance at the ingredients list will often expose questionable products at a glance.
Trust in scientifically validated, certified products instead of risky budget buys.
4 Trust in Five Key Quality Criteria

Our testing reveals a clear pattern: Truly convincing results only come from whitening kits that meet five essential quality benchmarks. By focusing on these features, you protect your teeth and gums – and you’ll see rapid, visible results.
The Most Important Quality Markers
Only teeth whitening kits with these qualities delivered impressively consistent results in our tests. If you care about long-lasting, safe outcomes, don’t cut corners.
Avoid no-name bargains, miracle influencer products, and harsh home remedies – they have no place in your mouth. Penny-pinching in this area risks permanent damage to enamel and gums.
By choosing a certified whitening kit, you’re opting for proven ingredients, gentle use, and evenly white teeth, without unwelcome surprises.”
The 5 Best and Safest Teeth Whitening Kits in the 2026 Field Test
Test
(9.7/10)

36 Teeth Whitening Kits
02/2026

Test
(9.7/10)

36 Teeth Whitening Kits
02/2026

Pros
Cons
If you’re looking for effective and safe at-home whitening, the 2026 UK test winner is hard to beat. The Smilebite kit sets new standards and achieved the best overall results of all 36 products we examined.
The combination of an evidence-based active formula, outstanding safety profile, and tooth-friendly LED technology clearly sets this kit apart from many competitors. No other product in our test field delivered similarly strong, fast, and even whitening.
While numerous rival kits revealed quality or safety shortcomings, Smilebite manages an impressive balance of efficacy and oral health.
We therefore awarded an overall score of 96.6 percent and the grade “Excellent”. For readers who don’t want to compromise on their whitening, the test winner is the most consistent choice.
Detailed Test Results
On the core criterion, whitening power, Smilebite demonstrated what is currently achievable in at-home use.
After just one application, the clear majority of test participants already showed a measurable lightening of tooth shade.
Within around seven days, average gains were 4 to 6 shades on the established VITA scale. After two weeks, and where initial staining was pronounced, individual cases reached improvements of up to 8 shades.
These results are comparable to those typically associated with professional in-office whitening.
Particularly striking versus the competition was the uniformity of the outcome. Whereas other kits in our test frequently produced patchy results or yellow “border zones,” Smilebite delivered seamless brightness — even on harder-to-reach surfaces. Here, the precision brush proved notably effective and gentle on the gums.
Our test participants and accompanying experts agreed: The whitening result is consistently convincing: fast, streak-free, and long-lasting.
During testing, many competing products disappointed due to bulky, oversized trays and cumbersome gel application.
Capsule- and syringe-based systems were especially problematic: the gel was often distributed imprecisely and in excessive amounts, causing unnecessary gum contact and irritation.
Smilebite, by contrast, impressed with a well-thought-out application concept.
- The integrated mouth tray is comfortable, stays firmly in place, and fit markedly better than the clunky trays supplied with many rivals.
- The kit uses a precision brush, allowing the gel to be applied sparingly and exactly where needed. This minimizes consumption, prevents streaks, and supports a clean, controlled result.
- Hygiene and comfort are further enhanced by the splash-resistant design.
- Battery life, charging speed, and handling also outperformed many low-cost kits in our comparison.
- The automatic shut-off (15 minutes for blue light, 10 minutes for combined blue/red light) reliably protects against overuse and associated irritation.
The only significant drawback: The sensitive touch button occasionally registered as too delicate in our test.
A single critical look at the label is enough to distinguish Smilebite from many competitors.
Whereas a large number of other products rely on aggressive and potentially harmful substances such as hydrogen peroxide, chlorine compounds, titanium dioxide, or parabens (which can contribute to sensitivity, blotchy results, or even enamel damage), Smilebite systematically avoids such high-risk ingredients.
As a result, the kit fulfills a central quality requirement for modern home whitening: maximum effectiveness combined with the best possible level of safety.
- Smilebite contains a total of 9 ingredients: Aqua, glycerin, propylene glycol, phthalimidoperoxycaproic acid (PAP), hydroxylapatite, carbomer, cocos nucifera oil, menthol, xylitol.
- Main active ingredient: Phthalimidoperoxycaproic Acid (PAP) is used as the central whitening agent. Based on current scientific knowledge, PAP is considered a safe, effective, and gentle alternative to peroxides. In our test, it delivered strong whitening performance while keeping risks to enamel and oral tissues low.
- Additional beneficial ingredients:
– Hydroxyapatite protects and remineralizes the tooth surface, filling microscopic cracks and noticeably reducing sensitivity.
– Cocos nucifera (coconut) oil has antibacterial properties and improves mouthfeel after treatment.
– Xylitol helps protect against cavities and supports a healthy oral environment.
– Menthol provides a pleasant freshness during and after use. - Questionable ingredients: None. Smilebite completely avoids aggressive bleaches (high peroxide levels, chlorine compounds), optical brighteners such as titanium dioxide, hormonally active parabens, triclosan, or unnecessarily irritating surfactants. Highly abrasive polishing agents (which often contribute to irreversible enamel loss) are also absent.
Taken together, the scientifically grounded formula is sensibly composed from a medical standpoint and consistently avoids any additives that could harm dental health or burden sensitive users.
Among all teeth whitening kits we tested, Smilebite currently offers the best safety profile.
Across the review cycle, the sentiment toward the Smilebite LED Teeth Whitening Kit was highly positive. The documented recommendation rate is the highest in the entire comparison.
Consumers particularly highlight the rapid and clearly visible whitening. The comfortable handling and even, streak-free results are also frequently praised.
Unlike many competing products, users rarely report side effects: pain, irritation, or sensitivity were not documented during the test period.
Negative feedback about lack of effect or uneven results, which we occasionally saw with other products, was completely absent for Smilebite.
User feedback therefore confirms our lab findings: Smilebite performs not only under controlled test conditions but also in day-to-day use, with consistently high efficacy and tolerability.
The combination of a moderate price and superior performance across all test categories puts Smilebite at the top of our value-for-money ranking as well.
Cheaper kits in the test field often suffered from serious quality deficits and safety risks.
More expensive products, on the other hand, failed to justify their price through stronger results or better tolerability. In many cases, unwieldy trays, problematic ingredients, or critical user reports led to downgrades.
Our systematic evaluation of all criteria shows that Smilebite offers the most coherent overall package – not just in its price segment, but across the entire test field. Consumers receive a whitening kit that delivers on all relevant quality points while avoiding the well-known weaknesses of many competitors.
Our price verdict: In terms of quality, whitening performance, and durability, there is no more convincing choice in the current comparison test.


Pros
Cons
SmilePro is the strongest challenger to our test winner. It impressed with modern blue/red LED technology, precise brush application, and an effective PAP formula supported by hydroxyapatite and potassium nitrate.
In testing, teeth lightened by an average of four to five shades, with individual cases reaching up to eight shades. Results remained streak‑free.
Points were deducted for the two parabens in the formula, the English‑only product communication, and somewhat longer delivery times.
With a score of 93 percent and the rating “Very good”, SmilePro is a solid alternative to the test winner — suitable for anyone seeking powerful whitening and advanced technology who is prepared to accept a few minor trade‑offs.
Detailed Test Results
In practical use, SmilePro lightened tooth colour by an average of four to five VITA shades within one week; in some cases with heavy initial staining, we recorded improvements of up to eight shades.
The gel could be placed very precisely thanks to the brush applicator, producing a homogeneous, streak‑free result.
The whitening effect set in quickly: first visible changes were often noticeable after the second application.
Across the entire observation period, the lighter tooth shade remained stable and did not show signs of re‑staining.
In direct comparison, this places the kit just behind Smilebite, while clearly outperforming all other competitors in our test group.
The flexible silicone mouth tray adapts well to the teeth, provides even illumination with strong blue and red light, and switches off automatically after 10 minutes.
The gel is dispensed via a click‑pen mechanism. Dosing is accurate, but it does require a slightly steadier hand than the twist‑pen system used by the test winner.
The LED tray is waterproof, and in our testing the battery lasted for eight sessions without recharging.
Criticisms: The device’s touch button often responded sluggishly in our trial. In addition, the user manual, online service portal, and website are available only in English. Delivery took five working days and was therefore somewhat slower than for many other kits in the test.
SmilePro uses a formula without strongly oxidizing bleaching agents, relies on PAP, and includes several care‑oriented additives. Overall, the kit performed consistently well in our tolerability checks.
- Total of 19 ingredients: Sorbitol, aqua, phthalimidoperoxycaproic acid (pap), propylene glycol, glycerin, PEG 8, potassium nitrate, hydroxyapatite, cellulose gum, hydroxyethyl cellulose, xanthan gum, sodium saccharin, menthol, methylparaben, aloe barbadensis leaf juice, chamomilla recutita (matricaria) leaf extract, punica granatum seed oil, sodium bicarbonate, propylparaben.
- Main active ingredient: Phthalimidoperoxycaproic acid (PAP).
- Additional beneficial ingredients: Hydroxyapatite, potassium nitrate, and sodium bicarbonate support dental health, reduce sensitivity, and contribute to remineralization. Chamomile, aloe vera, and pomegranate extracts provide additional soothing effects for the gums.
- Questionable ingredients: Methylparaben and propylparaben are suspected of having hormonal (endocrine) activity, but in this product they are used below legal limit values.
Apart from the two added parabens, the formulation appears safe and effective overall.
The overall mood in our review cycle is predominantly positive. Many users report rapid, clearly visible whitening and appreciate the low‑risk application without noticeable irritation or pain.
The comfortable tray, streak‑free results, and 30‑day money‑back guarantee are frequently highlighted as advantages, as the guarantee makes trying the product easier.
Occasionally, users criticized the fact that instructions and customer service are available only in English, which can pose challenges for people with limited language skills.
With a list price of £100, SmilePro is positioned in the highest price segment. During our test period, however, the kit was regularly offered at a reduced price of around £50, which significantly improved its value for money.
Given its whitening performance, comfort, and technical features, the product is very attractive at this discounted price in our comparison.
The 30‑day money‑back guarantee is another plus, although it does require customers to cover return shipping costs.
Overall, particularly when purchased during promotions, the value for money is best described as very good.


Pros
Cons
UniqueSmile scores with powerful blue LEDs and precise brush application. The formula is high quality, free from aggressive bleaching agents, and includes remineralizing additives.
In terms of whitening strength, it trails the front-runners, with average gains of two to five shades in our test.
Deductions were made for PEG‑8, the parabens, the lack of water protection, and the somewhat inconvenient wired tray. Red light is also missing.
With 85 percent and a rating of “Very good”, UniqueSmile is a strong but only moderately convenient choice — well suited to anyone who values intensive LED illumination and precise gel placement, but does not expect perfect equipment or maximum whitening power.
Detailed Test Results
In our trial, UniqueSmile produced visible whitening of two to three shades within a few days; after two weeks, depending on the initial level of discolouration, up to five shades were achievable.
The whitening effect was free from blotches – largely thanks to targeted brush application and the strong light intensity. The lighter tooth shade remained stable throughout the test period.
In direct comparison, UniqueSmile lagged behind Smilebite and SmilePro, but still clearly outperformed many other kits in the field.
UniqueSmile’s handling benefits from the precision brush, which allows the gel to be distributed accurately even on hard-to-reach tooth surfaces.
The powerful LED supports rapid, even activation of the active ingredients and makes a tangible contribution to the streak-free result. However, UniqueSmile does without a red-light spectrum, so potentially soothing, anti-inflammatory effects are absent.
The fixed, integrated mouth tray offers a reasonable fit, but the wired connection proved repeatedly inconvenient in our test and noticeably reduced comfort. The lack of water resistance also makes quick, hygienic cleaning more cumbersome.
UniqueSmile relies on a PAP-based formula, supplemented with remineralizing and soothing additives. Aggressive oxidizing agents or optical brighteners such as titanium dioxide are absent – a clear advantage.
- Total of 19 ingredients: Sorbitol, aqua, phthalimidoperoxycaproic acid (pap), propylene glycol, glycerin, potassium nitrate, PEG 8, hydroxyapatite, cellulose gum, hydroxyethyl cellulose, xanthan gum, saccharin sodium, menthol, methylparaben, aloe barbadensis leaf juice, chamomilla recutita extract, punica granatum seed extract, sodium bicarbonate, propylparaben.
- Main active ingredient: Phthalimidoperoxycaproic acid (PAP).
- Additional beneficial ingredients:
- Hydroxyapatite (remineralization),
- Potassium nitrate (helps protect against sensitivity),
- Sodium bicarbonate (pH buffer),
- Aloe vera and chamomile (soothing),
- Punica granatum (pomegranate) extract (antioxidant),
- Menthol (freshness).
- Questionable ingredients:
- PEG‑8 (may increase the permeability of mucous membranes),
- Methylparaben and propylparaben (possible hormonal activity cannot be ruled out). The concentrations remain below statutory limits but are, in our view, dispensable.
Apart from PEG‑8 and the two parabens, the formulation shows a good safety profile; high‑risk substances are absent. Readers wishing to avoid parabens entirely will find a consistently cleaner alternative in Smilebite.
Overall sentiment in our review cycle is predominantly positive. Consumers praise the rapid whitening, fresh taste, and precise brush application; many reviews explicitly highlight the streak-free results.
Critical voices mainly point to the cable, which restricts movement, and in some individual cases to less brightness than expected. Reports of marked sensitivity or pain are rare and were not observed in our own trial.
The recommendation rate is above the industry average, but does not quite reach the top scores achieved by the test winner Smilebite.
UniqueSmile sits in the mid-price range but delivers somewhat less whitening power than the leading kits.
Our scoring model nonetheless rates the value for money as good, because the strong LED and precise brush application add genuine benefits.
However, the missing water protection, blue‑only light technology, and the cable connection – which test participants often found irritating – temper this advantage and place the kit behind Smilebite and SmilePro overall.
For users who value higher light output and are willing to accept the extra cost, UniqueSmile is a solid, though not the most economical, option.


Pros
Cons
Ualans delivers respectable whitening performance, a safe PAP-based formula, and the relatively rare combination of blue and red LED light.
Application is straightforward: The tray sits comfortably, and the gel can be distributed precisely with the brush.
However, we applied significant deductions for defects in the touch button, occasionally underfilled gel pens, and a virtually unreachable manufacturer. These service and quality issues undermine what is otherwise a good overall impression.
With 82.4 percent and a rating of “Good”, Ualans lags behind the top kits but remains a budget-friendly option for users seeking quick results — provided they are willing to accept potential quality and comfort risks.
Detailed Test Results
On average, Ualans brightened teeth by two to three VITA shades after only three applications; after two weeks, some participants achieved gains of up to five shades.
The combination of PAP gel, powerful blue light, and supplementary red light clearly accelerated the reaction and produced an even, streak-free result. Thanks to the brush application, the gel was well controlled, and border zones or excess gel did not irritate the gums.
In direct comparison, performance was slightly below SmilePro and markedly behind Smilebite, but still better than that of most other kits in the test.
The achieved brightness remained largely stable throughout the observation period, although we noted slight re-staining toward the end.
Overall, the Ualans kit is easy to use: The brush allows targeted, clean application of the gel onto the teeth.
The LED tray has a comfortable shape, combines strong blue and red light, and features an automatic 10 minute timer.
However, weaknesses became apparent in build quality. The heavily promoted touch button often reacted unreliably or not at all in our testing, costing time and patience. In addition, numerous buyers report further issues such as empty or only partially filled gel pens, as well as defective devices.
Because the manufacturer is based in Hong Kong, our test inquiries about complaints and support went unanswered. These shortcomings considerably diminish the otherwise positive overall impression.
The Ualans Home Whitening Kit uses a modern, streamlined formulation that deliberately avoids critical or strongly irritating substances, but it also omits some of the particularly beneficial care additives – such as hydroxyapatite – seen in other top kits.
- Total of 10 ingredients: Sodium bicarbonate, glycerin, propylene glycol, deionized water, carbomer, carboxymethyl, triethanolamine, polyvinylpyrrolidone, menthol, phthalimidoperoxycaproic acid (PAP).
- Additional beneficial ingredients:
– Sodium bicarbonate helps neutralize acids.
– Menthol provides a fresh mouthfeel. - Questionable ingredients: None identified in our assessment. Ualans consistently avoids aggressive bleaches, optical brighteners such as titanium dioxide, parabens, or triclosan.
Overall, the formulation is clean and solid with a favorable safety profile. At the same time, it lacks enamel-supporting extras such as hydroxyapatite or xylitol, which could further remineralize and protect tooth surfaces.
Feedback on the Ualans kit is mixed. Many users confirm good whitening results and easy handling.
At the same time, frequent complaints relate to defects in the sensitive touch button and to partially filled or even empty gel pens. Several customers also report difficulties contacting the manufacturer regarding complaints; support inquiries usually went unanswered.
The kit is occasionally hard to obtain, as availability fluctuates. Some consumers also describe absent results or more pronounced side effects – potential explanations include inconsistent production batches or counterfeit products in circulation.
Despite generally decent ratings, this cluster of quality and service issues led to score reductions in our test.
The Ualans Home Whitening Kit is positioned in the lower price segment and, for the price, offers solid whitening performance plus dual spectrum LED technology. The basic ratio of purchase cost to achieved brightening is therefore positive.
However, the high defect rate for the touch button and gel pens, along with limited customer service, reduces this cost advantage. Compared to better built competitors, users must expect compromises in comfort and support with Ualans.
For those who can live with potential quality shortcomings and mainly want affordable whitening results, the kit still represents a broadly reasonable offer.


Pros
Cons
Colgate’s LED Whitening Kit delivered solid but unspectacular results in our test, with maximum gains of around four shades — clearly behind the leading PAP-based products. For those specifically seeking a peroxide-based alternative, this kit offers a legally compliant option from a well-known brand.
Strengths include the powerful LED and straightforward brush application. On the negative side, we noted the rapid hardening of the gel, the simple wired tray, and the limited scope of supply. Replacement pens are expensive, and in our assessment the brand name alone does not justify the surcharge.
With 72.1 percent and a rating of “Satisfactory”, Colgate remains a serviceable alternative for consumers who deliberately wish to avoid PAP — but with clear compromises in performance, comfort, and value for money.
Detailed Test Results
In our test, the Colgate LED Whitening Kit achieved moderate to good results. After a few applications, improvements of one to two shades were common; after two weeks, individual cases reached up to four VITA shades.
Whitening was consistently even and streak-free, thanks primarily to the precise brush applicator.
Overall, however, performance lagged behind the more powerful PAP kits. The hydrogen peroxide content is limited to 0.1% — the legal maximum for over-the-counter products in the EU — and this low dose restricts the potential effect.
For heavier or deeper discolourations, the desired outcome often failed to materialize. For users who do not wish to use PAP or have not been satisfied with it, Colgate nevertheless offers a permissible peroxide-based alternative.
Handling of the Colgate kit is straightforward: The whitening gel can be applied accurately using the integrated brush, and the strong blue LED provides sufficient light activation.
However, the built-in mouth tray appears simply made and can only be used with a cable, which noticeably limits freedom of movement and practical comfort compared with wireless devices.
In our test, the gel dried and hardened quickly when exposed to air — a property not seen in any other gel. We were not able to determine whether similar hardening might also occur in the oral cavity.
Despite the prominent brand, packaging and build quality leave a basic impression: the plastic components feel rather flimsy, and the kit includes only a single whitening pen. For occasional use, the equipment is adequate, but it falls short of what more demanding users might expect.
Colgate takes a minimalist approach with just five declared components. The formula is based on low dose hydrogen peroxide and avoids dyes, parabens, PEG emulsifiers, and titanium dioxide.
- Total of Five ingredients: Aqua, hydrogen peroxide, alcohol, acrylates/octylacrylamide copolymer, benzoic acid.
- Main active ingredient: Hydrogen peroxide (0.1%) – the legally permitted maximum for over-the-counter products; it acts oxidatively on surface stains.
- Additional beneficial ingredients: Benzoic acid functions as a mild preservative with some antimicrobial activity.
- Questionable ingredients: Alcohol (alcohol denat.) can dry out mucous membranes and may irritate sensitive users. The remaining ingredients are considered acceptable at the stated levels.
The formulation is clear and peroxide based, without highly controversial additives. The low peroxide level reduces potential risks but also limits whitening power compared with PAP kits. Alcohol counts as a minor negative factor; overall, the safety profile is still acceptable.
Feedback on the Colgate LED Whitening Kit is mixed. Many users report only modest or absent whitening, which some attribute to the low active-ingredient concentration.
Positive comments often mention the simple application and the reassurance of a familiar brand. Common criticisms focus on the perceived low material quality and the limited supply of gel. Problems with returns and complaints are also reported, despite the manufacturer’s prominence.
A portion of the reviews originates from Amazon’s Vine program, where testers receive the product in exchange for feedback. This may influence the objectivity of some individual ratings.
The Colgate LED Whitening Kit sits in the upper price bracket without, in our view, sufficiently justifying its premium through whitening performance or equipment.
The well-known brand name is reflected more in the price than in functionality, scope of supply, or material quality. In direct comparison, modern kits with more potent formulas and richer equipment offer better overall value. The limited yield and lean configuration underscore the gap between cost and return.
For consumers specifically seeking a peroxide-based alternative to PAP kits, Colgate remains the most widely recognized option – but one that comes with clear trade-offs in terms of value for money.
Direct Comparison: The 5 Top Teeth Whitening Kits of 2026
| Test results in comparison |
1st place SmileBite 
|
2nd place SmilePro 
|
3rd place UniqueSmile 
|
4th place Ualans 
|
5th place Colgate 
|
|---|---|---|---|---|---|
| Brand | SmileBite | SmilePro | UniqueSmile | Ualans | Colgate |
| Brand reputation | Very good | Good | Good | Fair | Very good |
| Overall verdict | 9.7/10 (Excellent) |
9.3/10 (Very good) |
8.5/10 (Very good) |
8.2/10 (Good) |
7.2/10 (Satisfactory) |
| Whitening of up to* | 8 shades | 8 shades | 5 shades | 5 shades | 4 shades |
| Whitening performance | 9.5/10 | 9.0/10 | 8.0/10 | 8.2/10 | 7.5/10 |
| Ingredients & safety | 9.8/10 | 9.0/10 | 9.0/10 | 8.3/10 | 6.5/10 |
| Use & build quality | 9.6/10 | 9.5/10 | 8.1/10 | 8.5/10 | 8.1/10 |
| Value for money | 9.7/10 | 9.6/10 | 8.9/10 | 9.1/10 | 6.6/10 |
| Main active ingredient | PAP | PAP | PAP | PAP | H₂O₂ 0.1 % |
| Contains hydroxyapatite | |||||
| Free from high-risk ingredients** | |||||
| Application system | Brush | Brush | Brush | Brush | Brush |
| Blue + red LEDs | |||||
| Session length | 10 min | 10 min | 10 min | 10 min | 10 min |
| Price level | ££ | ££ | ££ | £ | £££ |
| Buy original product | Shop safely | Shop safely | Shop safely | Shop safely | Shop safely |
*As always, both the time needed to see results and the degree of whitening will differ from person to person. Our assessments are informed by our own in-depth experience and a wide range of reputable external reviews.
**Risky Ingredients: In our view, these substances have no place in teeth whiteners. For full details, see “Which Ingredients Matter Most?” at the top of this article.
Warning: These 10 Kits Rated “Unsatisfactory” in Our Safety Check
During our 2026 teeth whitening test, we put dozens of products through an intensive safety check, carefully tracking all publicly available recalls. Some low-scoring products were purchased and tested directly by us. For others, we relied on official warnings or product recalls issued by European and national authorities.
Below, we outline the most concerning risk products in detail, their use is not recommended for your safety.
Ordered by us and rated critically:

Ordered anonymously (12/2024) and reviewed; subject to earlier product recalls in the EU.
Summary: Due to regulatory recalls, lack of transparency, no verifiable EU accountability, a positive peroxide test, and incomplete labeling, we had to severely downgrade this product. Health risks stemming from trust or quality deficiencies can’t be ruled out. We strongly advise against IVISMILE and similar no-name products.
Declared ingredients: PAP as main active, no mention of peroxide in tested batch’s gel.
Shortcomings: Packaging gave no clear contact address or clues to a European provider. Only the IVISMILE logo appeared on the LED device and syringes – no other manufacturer or importer data.
Background: IVISMILE has previously been recalled for excessive hydrogen peroxide (e.g., PSD case number: 2103-0294). IVISMILE acts as a supplier for “white label” products, making each EU importer liable for compliance.
Our readings: Peroxide test detected 5–8% in the gel. While PAP may show a false positive, readings this high strongly suggest substantial hydrogen peroxide content.

Ordered anonymously (12/2024) and tested.
Summary: Classic fake product, almost certainly containing banned, undeclared, and potentially hazardous ingredients. We emphatically warn against buying.
Declared ingredients: None that are proven effective — not even peroxide or PAP.
Analysis: Peroxide spot tests revealed high levels of hydrogen peroxide or similar chemicals. Numerous user reviews report severe irritation (burns, mucosal pain) or rapid whitening — both classic signs of unlisted peroxide, which is illegal for over-the-counter whitening.

Ordered anonymously (12/2024), but never delivered.
Conclusion: The source, quality, and even a refund process are unclear. If you order, you risk losing your money — and, if a shipment ever arrives, possibly your health.
Incidents: No shipment and no response to inquiries. No refund issued.
Fake indicators: Supposed glowing reviews likely stem from fakes or bots. Many complaints ring familiar: inflated bills, failed deliveries, aggressive up-selling, scam return policies, and shipment of unrelated products.

Ordered anonymously (06/2025) and tested.
Summary: Lacking everything: no listed ingredients, no company info, no safety instructions. We strongly advise against this kit.
Declared ingredients: None on the box.
Other issues: No ingredient label, no supplier info, and no warnings at all.
Analysis: Tests showed peroxide levels well above legal thresholds.

Ordered anonymously (12/2024) and assessed.
Summary: We strongly recommend you do not purchase.
Declared actives: Hydrogen peroxide and carbamide peroxide as main components.
Analysis: Detected peroxide or peroxide analogs in extremely high concentrations, between 50 and 80 times the permitted limit (0.1%). Two peroxides were listed, but testing confirmed large excesses.
Other products recalled by authorities (not purchased by us):
These whitening products triggered official recalls in the EU and other markets due to clear safety threats. Although we didn’t acquire them during our trial, their reputation is so compromised that we categorically advise against all such brands and white-label variants.
- Vaclav Teeth PRO Whitening Pen
- Alert no.: A12/00214/24 (Norway)
- Risk: 2.5% hydrogen peroxide (only 0.1% allowed), danger of burns and mucous injuries.
- Status: Blocked from sale.
- Dental 360 Advanced Teeth Whitening System
- Alert no.: A12/00213/24 (Norway)
- Hazard: 6.9% peroxide, massively above legal limit.
- Status: EU-wide sales ban.
- GlorySmile Teeth Whitening Pen
- Alert no.: 2405-0043 (UK)
- Risk: 0.9% peroxide, unknown manufacturer, considerable health danger.
- Belissas Whitening
- Alert no.: A12/00247/23 (Sweden)
- Risk: 7.5% peroxide, potential for severe mucosal/systemic effects.
- Status: Europe-wide recall.
- KISSION Teeth Whitening
- Alert no.: A12/01425/23 (France)
- Hazard: 7.7% peroxide, documented skin and mucous membrane reactions.
- Status: Recall; sale banned across major platforms like Amazon and eBay.
Important Safety Notes and Recommendations
- Health isn’t a gamble: Unclear origins, incomplete labeling, missing manufacturer details, and unapproved ingredients are a serious and unacceptable risk — especially when it comes to something in direct contact with your mouth, teeth, and nerves.
- Self-education pays: Always check the background of products before you buy – recent recalls are published by the EU Commission (“Safety Gate”), the German BfR, or national agencies (RAPEX, BfR, BVL, BfArM, GOV.UK).
- What to do if uncertain?
- Ask about origins, full ingredient list, batch markings, and your right to cancel.
- If any of this is missing — or if ads seem too good to be true, prices are suspiciously low, and user reviews all sound the same — skip the purchase.
Bottom line: Products flagged by official warnings, recalls, or untrue claims should never go near your mouth. Even seemingly well-declared products may be rebranded “white label” kits resold by new vendors multiple times per year. Your dental health must come first, always stick to trustworthy brands with transparent product management.
These Are the 36 Teeth Whitening Kits We Tested
- Smilebite LED Teeth Whitening Kit (96.7% – Test Winner)
- SmilePro LED Teeth Whitening Kit (93.0%)
- UniqueSmile LED Teeth Whitening Kit (84.8%)
- Ualans LED Teeth Whitening Kit (82.5%)
- Colgate LED Teeth Whitening Kit (72.1%)
- DiamondSmile LED Teeth Whitening Kit (71.9%)
- Dr.Dent.co LED Teeth Whitening Kit (71.2%)
- Beesjuy LED Teeth Whitening Kit (69.2%)
- OnlySmile LED Teeth Whitening Kit (64.7%)
- PearlSmile LED Teeth Whitening Kit (62.4%)
- PerlWeiss Whitening Set (DM)
- ESMILE Whitening Strips
- Uniquesmile Whitening Strips
- Pearlsmile Whitening Powder
- Glowee LED Teeth Whitening Kit
- OnlySmile Teeth Whitening Powder
- Alpine White Whitening Strips
- Shine Up Brightly White Teeth Whitening Strips
- Smilebite White Bite Color Corrector
- Smilebite The White(ning) Stripes
- HiSmile Colour Corrector v34
- Smilebite Light & Bright Pen
- Mybeaux Teeth Whitening Strips
- Slurerbe Professional Teeth Whitening Pen
- EZGO Teeth Whitening Strips
- HiSmile PAP+ Strips
- IVISMILE LED Teeth Whitening Kit (UNSATISFACTORY)
- Celakeety LED Teeth Whitening Kit (UNSATISFACTORY)
- WellaWhite LED Teeth Whitening Kit (UNSATISFACTORY)
- Pro White Whitening Strips (UNSATISFACTORY)
- Rechargeable LED Teeth Whitening Light Kit (UNSATISFACTORY)
- MySmile LED Teeth Whitening Kit (NO LONGER AVAILABLE)
- KU2 Cosmetics LED Teeth Whitening Kit (NO LONGER AVAILABLE)
- HiSmile LED Teeth Whitening Kit (NO LONGER AVAILABLE)
- Auraglow Complete LED Whitening Kit (NO LONGER AVAILABLE)
- Whitify LED Whitening Kit (NO LONGER AVAILABLE)
How We Scored: Our Transparent Testing and Rating Method
To keep our assessments as consumer-friendly and fair as possible, we designed a multi-step, transparent points system. Each key product dimension is scored separately, then combined into a clear overall result — so you can see, at a glance, how a kit earned its mark.
The rating framework in detail:
We evaluate both core and supporting ingredients – balancing proven whitening efficacy with overall safety.
- Primary actives: PAP (phthalimidoperoxycaproic acid) earns the top score (+75). Hydrogen peroxide (+70), carbamide (urea) peroxide (+65), and sodium chlorite (+50) are graded accordingly. Multiple actives don’t stack beyond a maximum of 75 points.
- Beneficial additives: Hydroxyapatite (+10), sodium bicarbonate (+8), xylitol (+8), and potassium nitrate (+5) contribute to remineralization, sensitivity relief, or cavity protection. Care ingredients such as aloe vera, coconut oil, chamomile, or pomegranate extract are also rewarded (+4 to +5 each). This block is capped at +25 points.
- Concerning additives: Titanium dioxide (–10), triclosan (–10), parabens (–5 per type), sodium lauryl sulfate (–5), and denatured alcohol/alcohol denat. (–5) are penalized for known risk profiles. Up to –50 points can be deducted here.
Extras (bonuses or penalties): Documented quality seals may add points; misleading claims can trigger deductions. Outcome: This category ranges from a maximum of 100 to a minimum of 0 points.
Here we assess handling, comfort, and technical execution using a standardized checklist.
- Light tech: Blue and red LEDs (+20), blue-only LEDs (+15), no LEDs (0). Light quality and intensity add up to +17 points.
- Power source: Built-in rechargeable battery (+17) scores higher than wired (+13) or disposable-battery devices (+10).
- Water resistance: At least splashproof, easy-to-clean designs earn a bonus (+10).
- Mouth tray: Integrated, comfortable, well-fitting trays (+17) outperform generic add-on trays.
- Gel application: A precision brush (+19) enables accurate dosing; syringes score (+17); capsules or tubes score (+13).
Extras (bonuses or penalties): We factor in documented defects or standout experiences where clearly evidenced. Overall range: 0 to 100 points.
Because results matter most, we score real-world whitening outcomes against practical benchmarks.
- Visible whitening: Up to +50 points for measurable shade gains.
- Speed: Up to +25 points for how quickly first visible results appear.
- Durability: Up to +25 points based on how well results hold after the course.
Note: Performance scores reflect our test experience and are not a guarantee. Individual outcomes vary, so treat our numbers as guidance rather than a promise.
We analyze both internal testing notes and external, credible user reviews.
- User ratings: We translate trustworthy, verified sources into a 0–100 index.
- Criticism and side effects: Documented complaints or adverse effects can incur deductions (up to –50 points).
We actively filter out reviews that appear fake, purchased, or otherwise unreliable.
We know cost matters. Our value metric blends performance with price using a formula that rewards high-performing kits at sensible prices:
Formula: Value-for-money points = (Total points / 400) × 75 + MIN(((Total points / 400)^2 × (75 / price) × 25), (Total points / 400) × 75 × 0.5)
This highlights products that deliver excellent performance at moderate cost. Cheap but weak kits won’t score well here.
Traceability and Fairness
We built this framework so you can easily see why a whitening kit earned a “Very Good,” “Good,” or “Unsatisfactory.” The structure reduces subjectivity by breaking complex judgements into clear, documented components – supporting safer, more informed comparisons.
Correct Use of Teeth Whitening Kits: Step-by-Step Guide
A careful, precise application is fundamental to achieving safe, effective teeth whitening. Our editorial team recommends following the steps below exactly. These guidelines are based on the latest findings from our practical testing and mirror widely accepted manufacturer instructions.
Step-by-Step Instructions
Before every application, brush your teeth thoroughly. Opt for a gentle toothpaste without harsh abrasives, ensuring you remove all plaque and debris without roughing up the enamel. Only clean tooth surfaces will allow the whitening gel to work evenly and prevent food or plaque from interfering with results. After brushing, wait about 10 minutes before applying the gel. This helps prevent sensitivity, since freshly brushed teeth can temporarily become more permeable.
The whitening gel should be applied only to visible tooth surfaces. A precision brush allows you to place the gel exactly where it’s needed, protecting sensitive gums and helping avoid wasteful overuse. With syringe- or capsule-based systems, aim for even distribution in the mouth tray – at no point should the gel touch the gums. Remove any excess gel from your gums or lips before switching on the tray; a clean cotton swab works best here.
Fit the mouth tray securely but comfortably over your teeth. It shouldn’t slip and should cover the entire area you want to whiten. Activate the LED unit according to the product’s instructions. Modern devices usually shut off automatically after 10 to 15 minutes – never extend the treatment time, as this may increase the risk of irritation or enamel damage.
When your session is up, remove the tray and rinse your mouth thoroughly with clean water. Clean the mouthpiece after each use. For long-lasting results, avoid staining foods and drinks – such as coffee, tea, juices, or red wine – for at least 30 to 60 minutes after treatment. Tobacco products should also be avoided where possible.
Most whitening treatments are intended for daily use over seven to fourteen days. Do not use them more than once per day to prevent irritation. After reaching your target shade, maintenance sessions every few months are usually sufficient. Remember: More frequent or prolonged use doesn’t boost whitening results, but it can harm your teeth over time.
Safety Information
If you experience pain, lasting sensitivity, gum irritation, or any other problems while using a whitening kit, discontinue use immediately and consult your dentist.
Do not use whitening products on areas with fillings, crowns, or other dental work that are visible – these materials will not change color.
These products are also not suitable for children, teenagers, or pregnant women.
Conclusion: Best Practices for At-Home Whitening
Taking the time to precisely follow each step, stick to recommended dosages and timings, and thoroughly clean both your mouth and the whitening device will help you achieve streak-free results while minimizing risks. Being diligent during the process increases both safety and success, significantly reducing your risk of sensitivity or dental damage.
If in doubt, it’s always a good idea to seek advice from your dental professional.
Frequently Asked Questions About Teeth Whitening Kits
There are a variety of reasons why whitening might not work as expected. The most common culprit is a formula with too little active ingredient, or one that simply isn’t effective – a frequent issue with lower-quality kits. If, after correct use over several days, you see no brightening at all, check the type of product you’re using (e.g., strips, pastes, or a formula with less than 0.1% peroxide, or without PAP).
Also keep in mind: Deep internal stains – sometimes caused by medications or root canal procedures – typically won’t respond well to over-the-counter options. If you’re not getting results with a quality whitening kit, have your dentist check for underlying issues.
Teeth whitening isn’t for everyone. Avoid using these products if you:
- Are a child or teenager (they should never use whitening kits).
- Have dental decay, leaking fillings, exposed tooth roots, or untreated gum disease.
- Are pregnant or breastfeeding.
- Have known allergies or sensitivities to any of the ingredients.
At-home whitening sets are mainly suitable for surface stains (such as those from coffee, tea, red wine, or tobacco). Stains embedded deep inside teeth, or those resulting from root canals (so-called intrinsic discolourations), are very unlikely to be lightened by non-prescription products.
Furthermore, dental work – veneers, crowns, fillings, and bridges – will never change colour. If you want to improve their appearance, only a dental professional can help.
Responsible, EU-approved whitening products with quality-tested formulations are generally safe for healthy teeth and gums when used as directed. All of the top-rated kits on our list are free from aggressive bleaches, high doses of peroxide, and banned substances.
If you choose questionable products — such as kits ordered via obscure online sellers, lacking full ingredient disclosure — you run the risk of burns, extreme sensitivity, and even lasting tooth damage.
Recalls and safety warnings are frequent in this segment! So, use only tested, well-labeled kits, following the instructions exactly, and never hesitate to consult your dentist if you have concerns or adverse effects.
Recommended treatment durations vary by product, but most home kits are designed for one treatment per day across seven to fourteen days. Each individual session usually lasts 10 to 15 minutes. Some manufacturers recommend longer or shorter intervals; just be sure to respect the stated maximums and always leave several months between full whitening courses.
With proper oral hygiene, the results typically last six to twelve months. If desired, the process can be repeated after that interval.
For best possible results, thoroughly clean your teeth before every session and always apply the gel to completely dry tooth surfaces. During a whitening regimen, try to avoid staining foods and drinks (coffee, tea, red wine, and curries) as well as smoking.
Be precise with dosage and application to prevent patchy results. Using a precision brush and a well-shaped mouth tray both help.
After your course of whitening, switch to a remineralizing toothpaste or oral care routine for the best long-lasting outcome.
Mild tingling or transient sensitivity can happen during whitening but should subside quickly. If you experience severe pain, persistent sensitivity, or gum irritation, discontinue use immediately and seek dental care.
Notably, products in our test that contain hydroxyapatite or potassium nitrate were especially effective at reducing these side effects and were generally much gentler overall.
Professional Teeth Whitening at the Dentist
If home whitening kits aren’t providing the results you want — or if your teeth present special challenges — professional, in-office whitening remains the gold standard. It’s especially well-suited for persistent discolouration, complex cases, and anyone who values strict safety oversight.
A dental practice begins by thoroughly checking the state of your teeth and gums. Next, your gums are meticulously protected, and a highly concentrated whitening gel is applied to the teeth – sometimes activated with a special light.
By law in the EU, in-office bleaching gels can contain up to 6% hydrogen peroxide; anything above that is only permitted for specific medical reasons and under direct dental supervision.
This entire process is precisely controlled to minimize the risk of side effects like heightened sensitivity or gum irritation. Thanks to both the expertise of dental staff and the use of professional-grade materials, first results are often visible right after the treatment.
Professional in-office whitening is considerably more expensive than home kits. Depending on the chosen system, a single session may range from €350 to €800. If a check-up and professional cleaning are necessary, costs can go up even further. Neither public nor private health insurance typically cover these expenses.
Professional whitening in the dental office is recommended if:
- You’ve tried several at-home treatments without success,
- You have especially tough, deep-set stains,
- Process safety and medical monitoring are your top priorities (such as with existing gum disease, tooth decay, or pronounced sensitivity),
- You need dental restorations — like old fillings, crowns, or veneers — matched or replaced for a uniform result.
For anyone with healthy teeth and just mild surface stains, a rigorously tested at-home whitening kit is often more than adequate.
Conclusion: Professional Whitening
An in-office bleaching session is the clearest, most reliable path to a quick, uniform, and safe whitening result — especially when home treatments have failed or personal dental needs are unusually complicated.
While this method offers more lasting results and thorough oversight, it does come at a higher cost. For straightforward cases and generally healthy teeth, carefully validated home whitening kits offer a perfectly reasonable solution.
Final Thoughts from Our Field Test
If you decide to whiten your teeth at home, do your research and avoid falling for empty promises or brand hype. Our extensive testing demonstrates that safe, effective, and easy-to-use teeth whitening kits do exist – but choosing wisely, based on clear quality criteria, is critical.
Modern LED-based kits using PAP as a core ingredient with additions like hydroxyapatite were standouts in our tests, while products with harsh chemicals or vague ingredient lists represented needless risks. Price alone is never a guarantee of quality – far more important are actual outcomes, safe application, and harmless ingredients.
By following best practices and sticking to recognised brands, most people can brighten their smiles at home without compromising their dental health. For complex dental challenges or stubborn tooth discolouration, professional whitening at your dentist’s office remains the definitive option.
Ultimately, your oral health is paramount – choose quality, safety, and proven trustworthiness above all.
- Smilebite Teeth Whitening Kit (9.7/10, rating “Excellent”): Strongest whitening in the test (up to eight shades), streak‑free with no yellow borders. LED tray with blue and red light, 10‑minute timer. PAP + hydroxyapatite; free from peroxide, titanium dioxide, and parabens. Highest recommendation rate. First choice for maximum effect and the best overall safety profile.
// - SmilePro Teeth Whitening Kit (9.3/10, rating “Very good”): Average whitening of four to five shades, in isolated cases up to eight shades. Advanced LED tray with blue and red light; precision brush prevents excess gel. PAP formula with hydroxyapatite, potassium nitrate, and sodium bicarbonate; does, however, contain methyl- and propylparaben, and all information is available only in English. 30‑day money‑back guarantee, somewhat longer delivery times. Recommended for powerful whitening with an overall high level of quality and safety.
// - UniqueSmile Teeth Whitening Kit (8.5/10, rating “Very good”): Whitening of up to five shades, LED tray with strong blue light, brush application. Formula almost identical to MySmile (also contains parabens and PEG‑8); wired tray, no red light. Suitable if you want very high LED intensity and accept the higher price.
// - Ualans Teeth Whitening Kit (8.2/10, rating “Good”): Whitening of two to five shades, PAP gel, LED tray with blue and red light, brush applicator. Clean formula without peroxide, parabens, or titanium dioxide; touch button prone to faults, weak manufacturer support. An option for budget‑conscious users who are prepared to accept certain quality risks.
// - Colgate Teeth Whitening Kit (7.2/10, rating “Satisfactory”): Moderate whitening of up to four shades, 0.1% hydrogen peroxide instead of PAP. LED tray with strong blue light, minimalist ingredient list without parabens, but only one gel pen included; tray is simple, price is high. An alternative if you specifically want a peroxide‑based branded solution and are willing to accept the additional cost.
- Newton, J. T. et al. (2021) ‘The impact of tooth colour on the perceptions of age and social judgements’, Journal of Dentistry, 112, 103771. https://pubmed.ncbi.nlm.nih.gov/34363891/ ↩︎
- British Dental Journal (2022) ‘The latest innovation in teeth whitening’, British Dental Journal, 232 (4), 280. https://www.nature.com/articles/s41415-022-4017-0 ↩︎
- Jamwal, N. et al. (2022) ‘Effect of whitening toothpaste on surface roughness and microhardness of human teeth: a systematic review and meta-analysis’, F1000Research, 11, 22. https://pubmed.ncbi.nlm.nih.gov/35265322/ ↩︎
- British Dental Journal (2022) ‘The latest innovation in teeth whitening’, British Dental Journal, 232 (4), 280. https://www.nature.com/articles/s41415-022-4017-0 ↩︎
- Müller-Heupt, L. K. et al. (2023) ‘Effectiveness and Safety of Over-the-Counter Tooth-Whitening Agents Compared to Hydrogen Peroxide In Vitro’, International Journal of Molecular Sciences, 24 (3), 1956. https://pmc.ncbi.nlm.nih.gov/articles/PMC9915942/ ↩︎
- Pascolutti, M. & de Oliveira, D. (2021) ‘A Radical-Free Approach to Teeth Whitening’, Dentistry Journal, 9 (12), 148. https://www.mdpi.com/2304-6767/9/12/148 ↩︎
- Limeback, H. et al. (2023) ‘Tooth Whitening with Hydroxyapatite: A Systematic Review’, Dentistry Journal, 11 (2), 50. https://pmc.ncbi.nlm.nih.gov/articles/PMC9955010/ ↩︎
- Pascolutti, M. & de Oliveira, D. (2021) ‘A Radical-Free Approach to Teeth Whitening’, Dentistry Journal, 9 (12), 148. https://www.mdpi.com/2304-6767/9/12/148 ↩︎
- Limeback, H. et al. (2023) ‘Tooth Whitening with Hydroxyapatite: A Systematic Review’, Dentistry Journal, 11 (2), 50. https://pmc.ncbi.nlm.nih.gov/articles/PMC9955010/ ↩︎
- Paszynska, E. et al. (2023) ‘Caries-preventing effect of a hydroxyapatite-toothpaste in adults: a 18-month double-blinded randomized clinical trial’, Frontiers in Public Health, 11, 1199728. https://www.frontiersin.org/articles/10.3389/fpubh.2023.1199728 ↩︎
- Haywood, V. B. et al. (2001) ‘Tray delivery of potassium nitrate-fluoride to reduce bleaching sensitivity’, Quintessence International, 32 (2), 105–109. https://pubmed.ncbi.nlm.nih.gov/12066670/ ↩︎
- Nayak, P. A. et al. (2014) ‘The effect of xylitol on dental caries and oral flora’, Clinical, Cosmetic and Investigational Dentistry, 6, 89–94. https://pmc.ncbi.nlm.nih.gov/articles/PMC4232036/ ↩︎
- Nayak, P. A. et al. (2014) ‘The effect of xylitol on dental caries and oral flora’, Clinical, Cosmetic and Investigational Dentistry, 6, 89–94. https://pmc.ncbi.nlm.nih.gov/articles/PMC4232036/ ↩︎
- Woolley, J. et al. (2020) ‘The effect of oil pulling with coconut oil to improve dental hygiene and oral health: a systematic review’, Heliyon, 6 (8), e04789. https://pmc.ncbi.nlm.nih.gov/articles/PMC7475120/ ↩︎
- Sujatha, G. et al. (2014) ‘Aloe vera in dentistry’, Journal of Clinical and Diagnostic Research, 8 (10), ZI01–ZI02. https://pmc.ncbi.nlm.nih.gov/articles/PMC4253296/ ↩︎
- Agarwal, A. et al. (2020) ‘Clinical and microbiological effects of 1% Matricaria chamomilla mouth rinse on chronic periodontitis: a double-blind randomized placebo-controlled trial’, Journal of Indian Society of Periodontology, 24 (4), 354–361. https://pmc.ncbi.nlm.nih.gov/articles/PMC7418554/ ↩︎
- European Parliament and Council (2009) ‘Regulation (EC) No 1223/2009 of 30 November 2009 on cosmetic products’, Official Journal of the European Union, L 342, 59–209. https://eur-lex.europa.eu/legal-content/DE/TXT/?uri=CELEX:32009R1223 ↩︎
- Kristensen, G. T. et al. (2021) ‘Survey and risk assessment of teeth-whitening products for personal use’, Survey of Chemical Substances in Consumer Products No. 186, Danish Environmental Protection Agency, 96 pp. https://www2.mst.dk/Udgiv/publications/2021/09/978-87-7038-340-0.pdf ↩︎
- Ablal, M. A. et al. (2013) ‘The whitening effect of chlorine dioxide—an in vitro study’, Journal of Dentistry, 41 (Suppl 5), e76–e81. https://pubmed.ncbi.nlm.nih.gov/23707537/ ↩︎
- Müller-Heupt, L. K. et al. (2023) ‘Effectiveness and safety of over-the-counter tooth-whitening agents compared to hydrogen peroxide in vitro’, International Journal of Molecular Sciences, 24 (3), 1956. https://pmc.ncbi.nlm.nih.gov/articles/PMC9915942/ ↩︎
- EFSA Panel on Food Additives and Flavourings (FAF) (2021) ‘Safety assessment of titanium dioxide (E171) as a food additive’, EFSA Journal, 19 (5), e06585, 130 pp. https://www.efsa.europa.eu/en/efsajournal/pub/6585 ↩︎
- European Commission (2022) ‘Commission Regulation (EU) 2022/63 of 14 January 2022 amending Annexes II and III to Regulation (EC) No 1333/2008 as regards the food additive titanium dioxide (E 171)’, Official Journal of the European Union, L 11, 1–5. https://eur-lex.europa.eu/eli/reg/2022/63/oj ↩︎
- Stiftung Warentest (2024) ‘Zahnpasta im Test: Gute Zahncremes – auch ohne Titandioxid’, test.de, 21 October 2024. https://www.test.de/Zahnpasta-im-Test-4607097-0/ ↩︎
- Weatherly, L. M. & Gosse, J. A. (2017) ‘Triclosan exposure, transformation, and human health effects’, Journal of Toxicology and Environmental Health, Part B: Critical Reviews, 20 (8), 447–469. https://pmc.ncbi.nlm.nih.gov/articles/PMC6126357/ ↩︎
- U.S. Food and Drug Administration (2024) ‘Skip the antibacterial soap; use plain soap and water’, FDA Consumer Updates, 12 December 2024. https://www.fda.gov/consumers/consumer-updates/skip-antibacterial-soap-use-plain-soap-and-water ↩︎
- European Commission (2024) ‘Commission Regulation (EU) 2024/996 of 3 April 2024 amending Regulation (EC) No 1223/2009 as regards Vitamin A, Alpha-Arbutin, Arbutin and certain substances with potential endocrine-disrupting properties in cosmetic products’, Official Journal of the European Union, L (4 April 2024), 1–8. https://eur-lex.europa.eu/legal-content/EN/TXT/?uri=OJ:L_202400996 ↩︎
- Bhasin, K. (2019) ‘Colgate Total toothpaste to relaunch – this time sans triclosan’, Bloomberg News, 15 January 2019. https://www.bloomberg.com/news/articles/2019-01-15/colgate-total-toothpaste-to-relaunch-this-time-sans-triclosan ↩︎
- European Commission (2014) ‘Commission Regulation (EU) No 358/2014 of 9 April 2014 amending Annexes II and V to Regulation (EC) No 1223/2009 on cosmetic products (Text with EEA relevance)’, Official Journal of the European Union, L 107, 5–9. https://eur-lex.europa.eu/legal-content/EN/TXT/PDF/?uri=CELEX:32014R0358 ↩︎
- Scientific Committee on Consumer Safety (SCCS) (2023) ‘Opinion on methylparaben (CAS No 99-76-3, EC No 202-785-7) – final version of 14 December 2023, corrigendum February 2024’, SCCS/1652/23, European Commission, Brussels, 109 pp. https://health.ec.europa.eu/system/files/2023-12/sccs_o_276_final.pdf ↩︎
- siehe Nr. 30 (EU-VO Nr. 358/2014) ↩︎
- Santos, G-C. et al. (2024) ‘Does a charcoal dentifrice interfere with enamel properties?’, Journal of Clinical and Experimental Dentistry, 16 (3), e243–e249. https://pmc.ncbi.nlm.nih.gov/articles/PMC11003290/ ↩︎
- AlShehri, A. et al. (2022) ‘OTC tooth-whitening powders and enamel microhardness’, Applied Sciences, 12, 6930. https://www.mdpi.com/2076-3417/12/14/6930 ↩︎
- Oral Health Foundation (2023) ‘Health charity explores the facts and myths of charcoal toothpaste’, News-Release, 16 Feb. 2023. https://www.dentalhealth.org/news/health-charity-explores-the-facts-and-myths-of-charcoal-toothpaste ↩︎
- EU-Safety-Gate (2024) RAPEX-Meldung A12/01425/23 – KISSION Teeth-Whitening. https://ec.europa.eu/safety-gate-alerts/screen/webReport/alertDetail/10011691?lang=en ↩︎
- Malki, M. et al. (2021) ‘pH-optimised peroxide gels preserve enamel microhardness during bleaching’, Journal of Dentistry, 110, 103693. https://pmc.ncbi.nlm.nih.gov/articles/PMC8700120/ ↩︎
- Wiegand, A. et al. (2021) ‘Internal pH and buffering capacity of saliva after use of whitening toothpastes’, Caries Research, 55 (4), 381–389. https://pubmed.ncbi.nlm.nih.gov/33615002/ ↩︎
- de Oliveira, R. C. et al. (2020) ‘Photobiomodulation with red-light reduces bleaching-induced hypersensitivity: randomised clinical trial’, Lasers in Medical Science, 35 (8), 1807–1815. https://pmc.ncbi.nlm.nih.gov/articles/PMC8233986/ ↩︎









